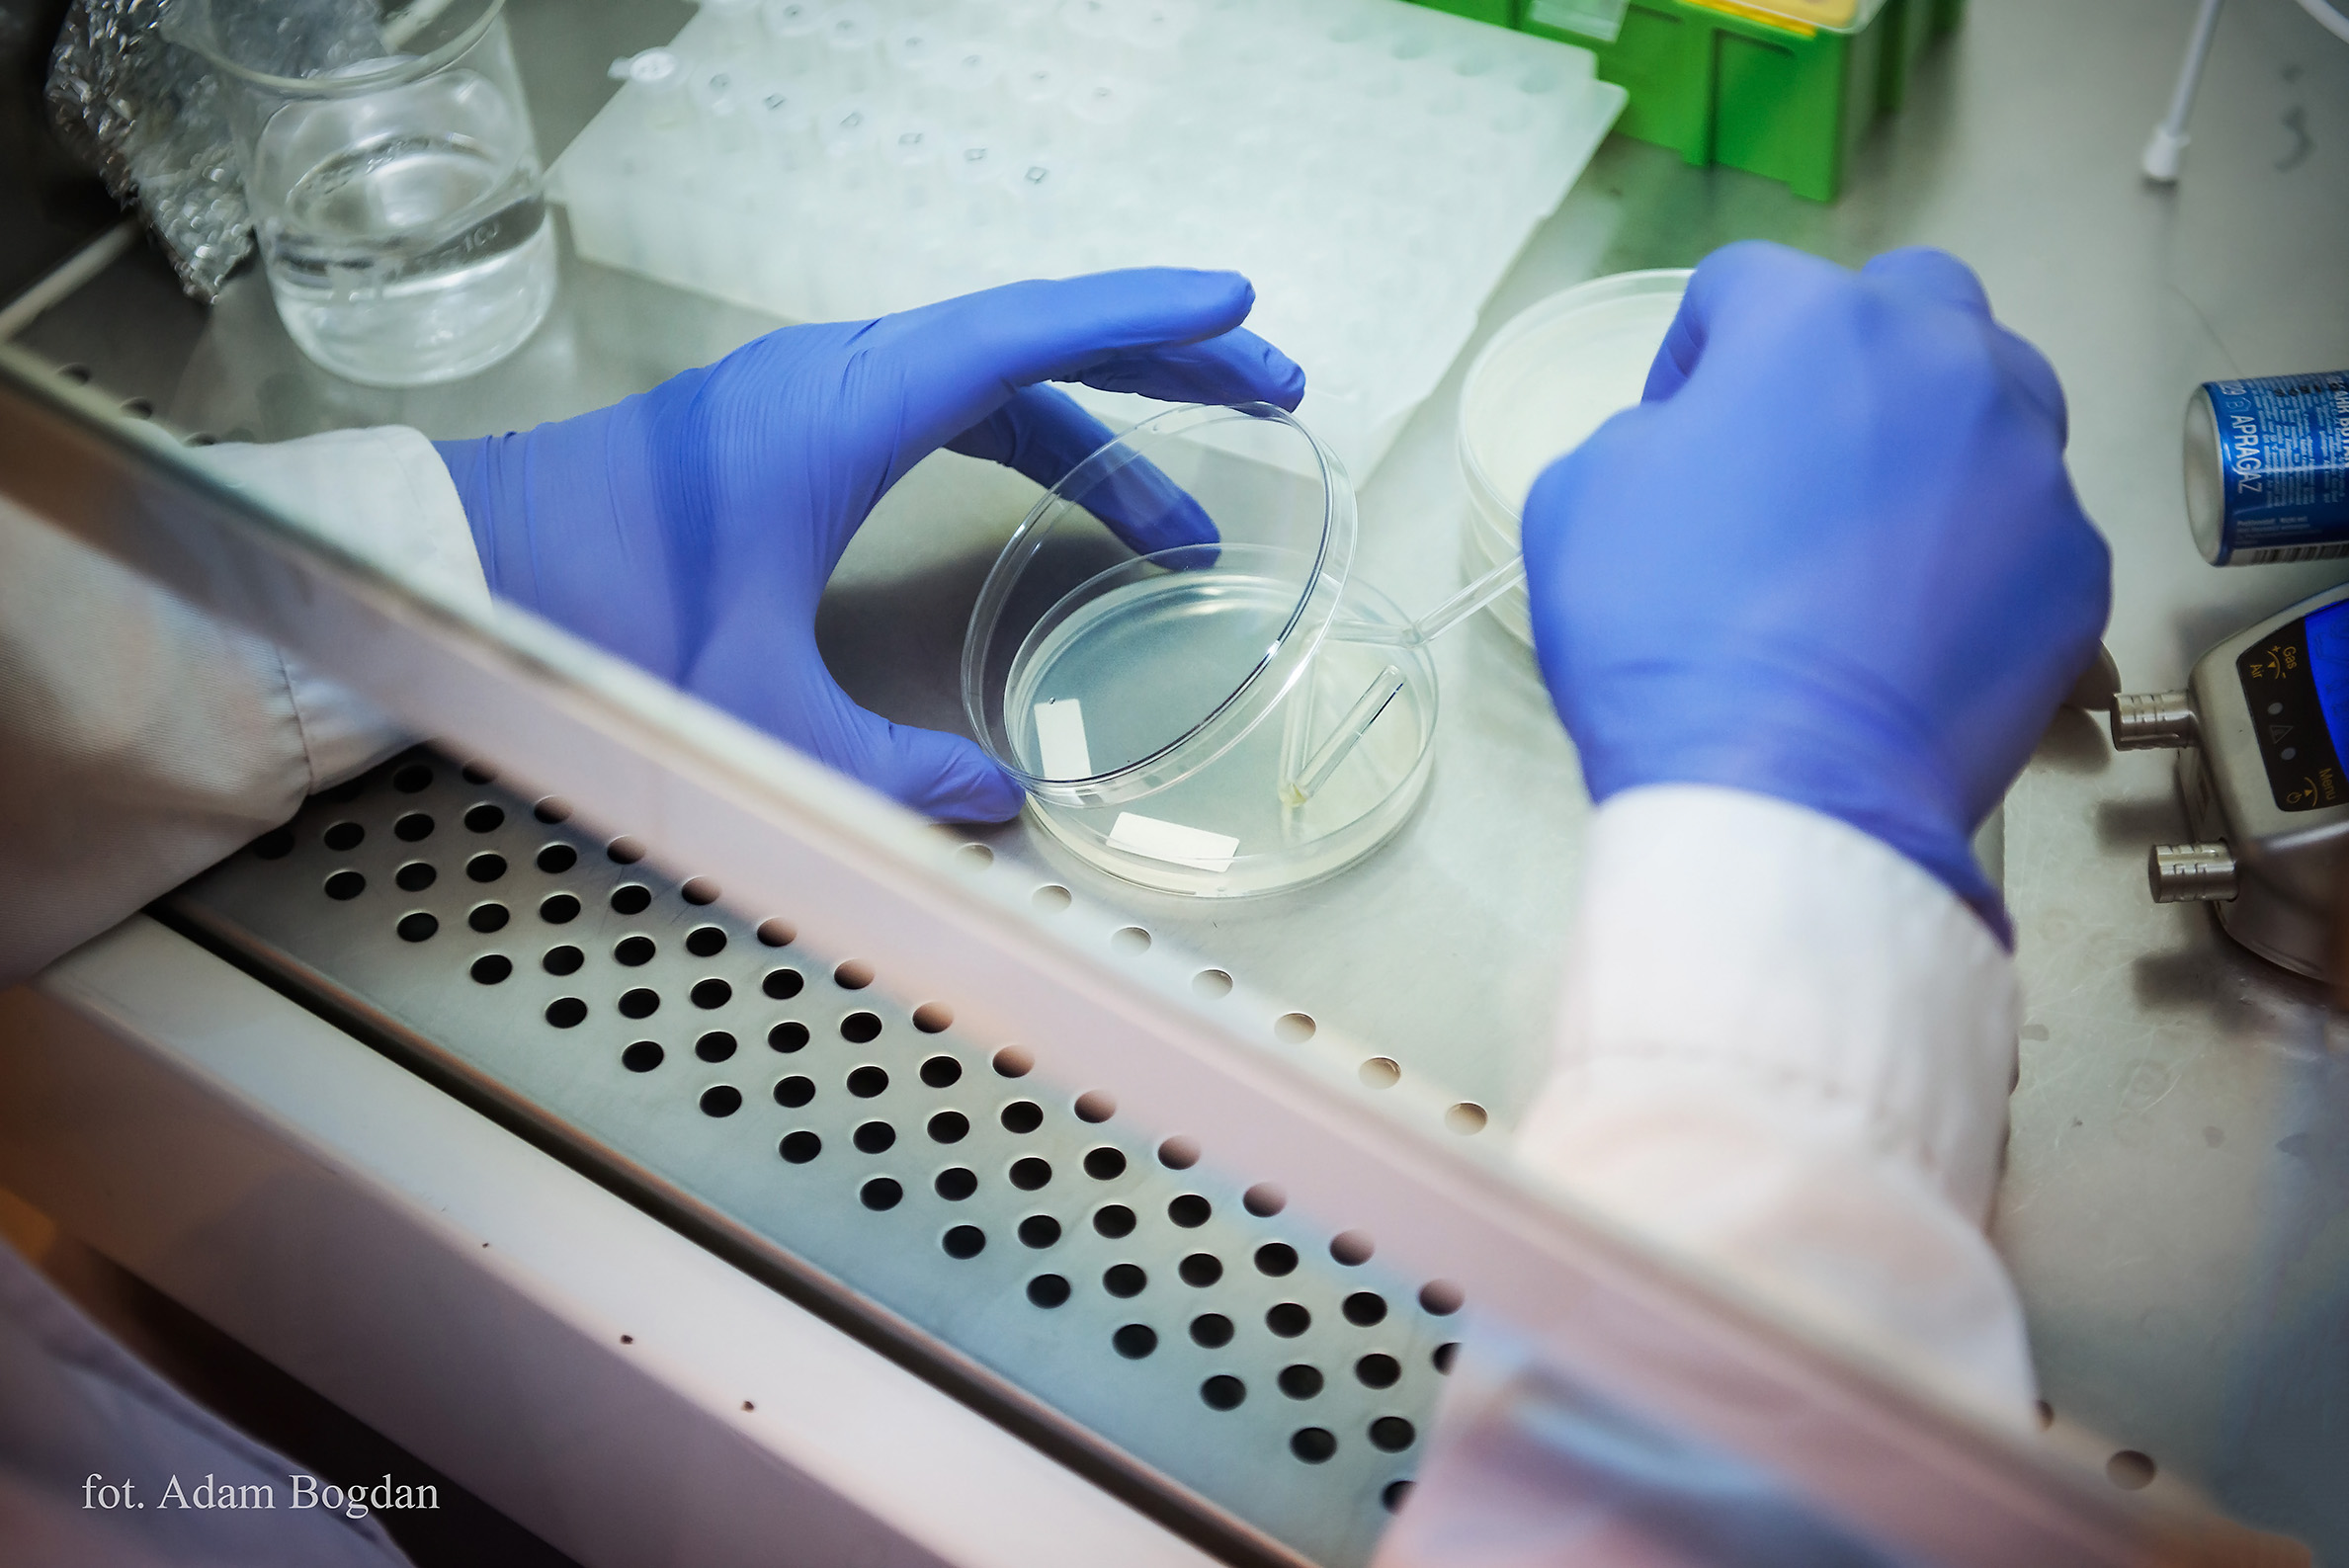
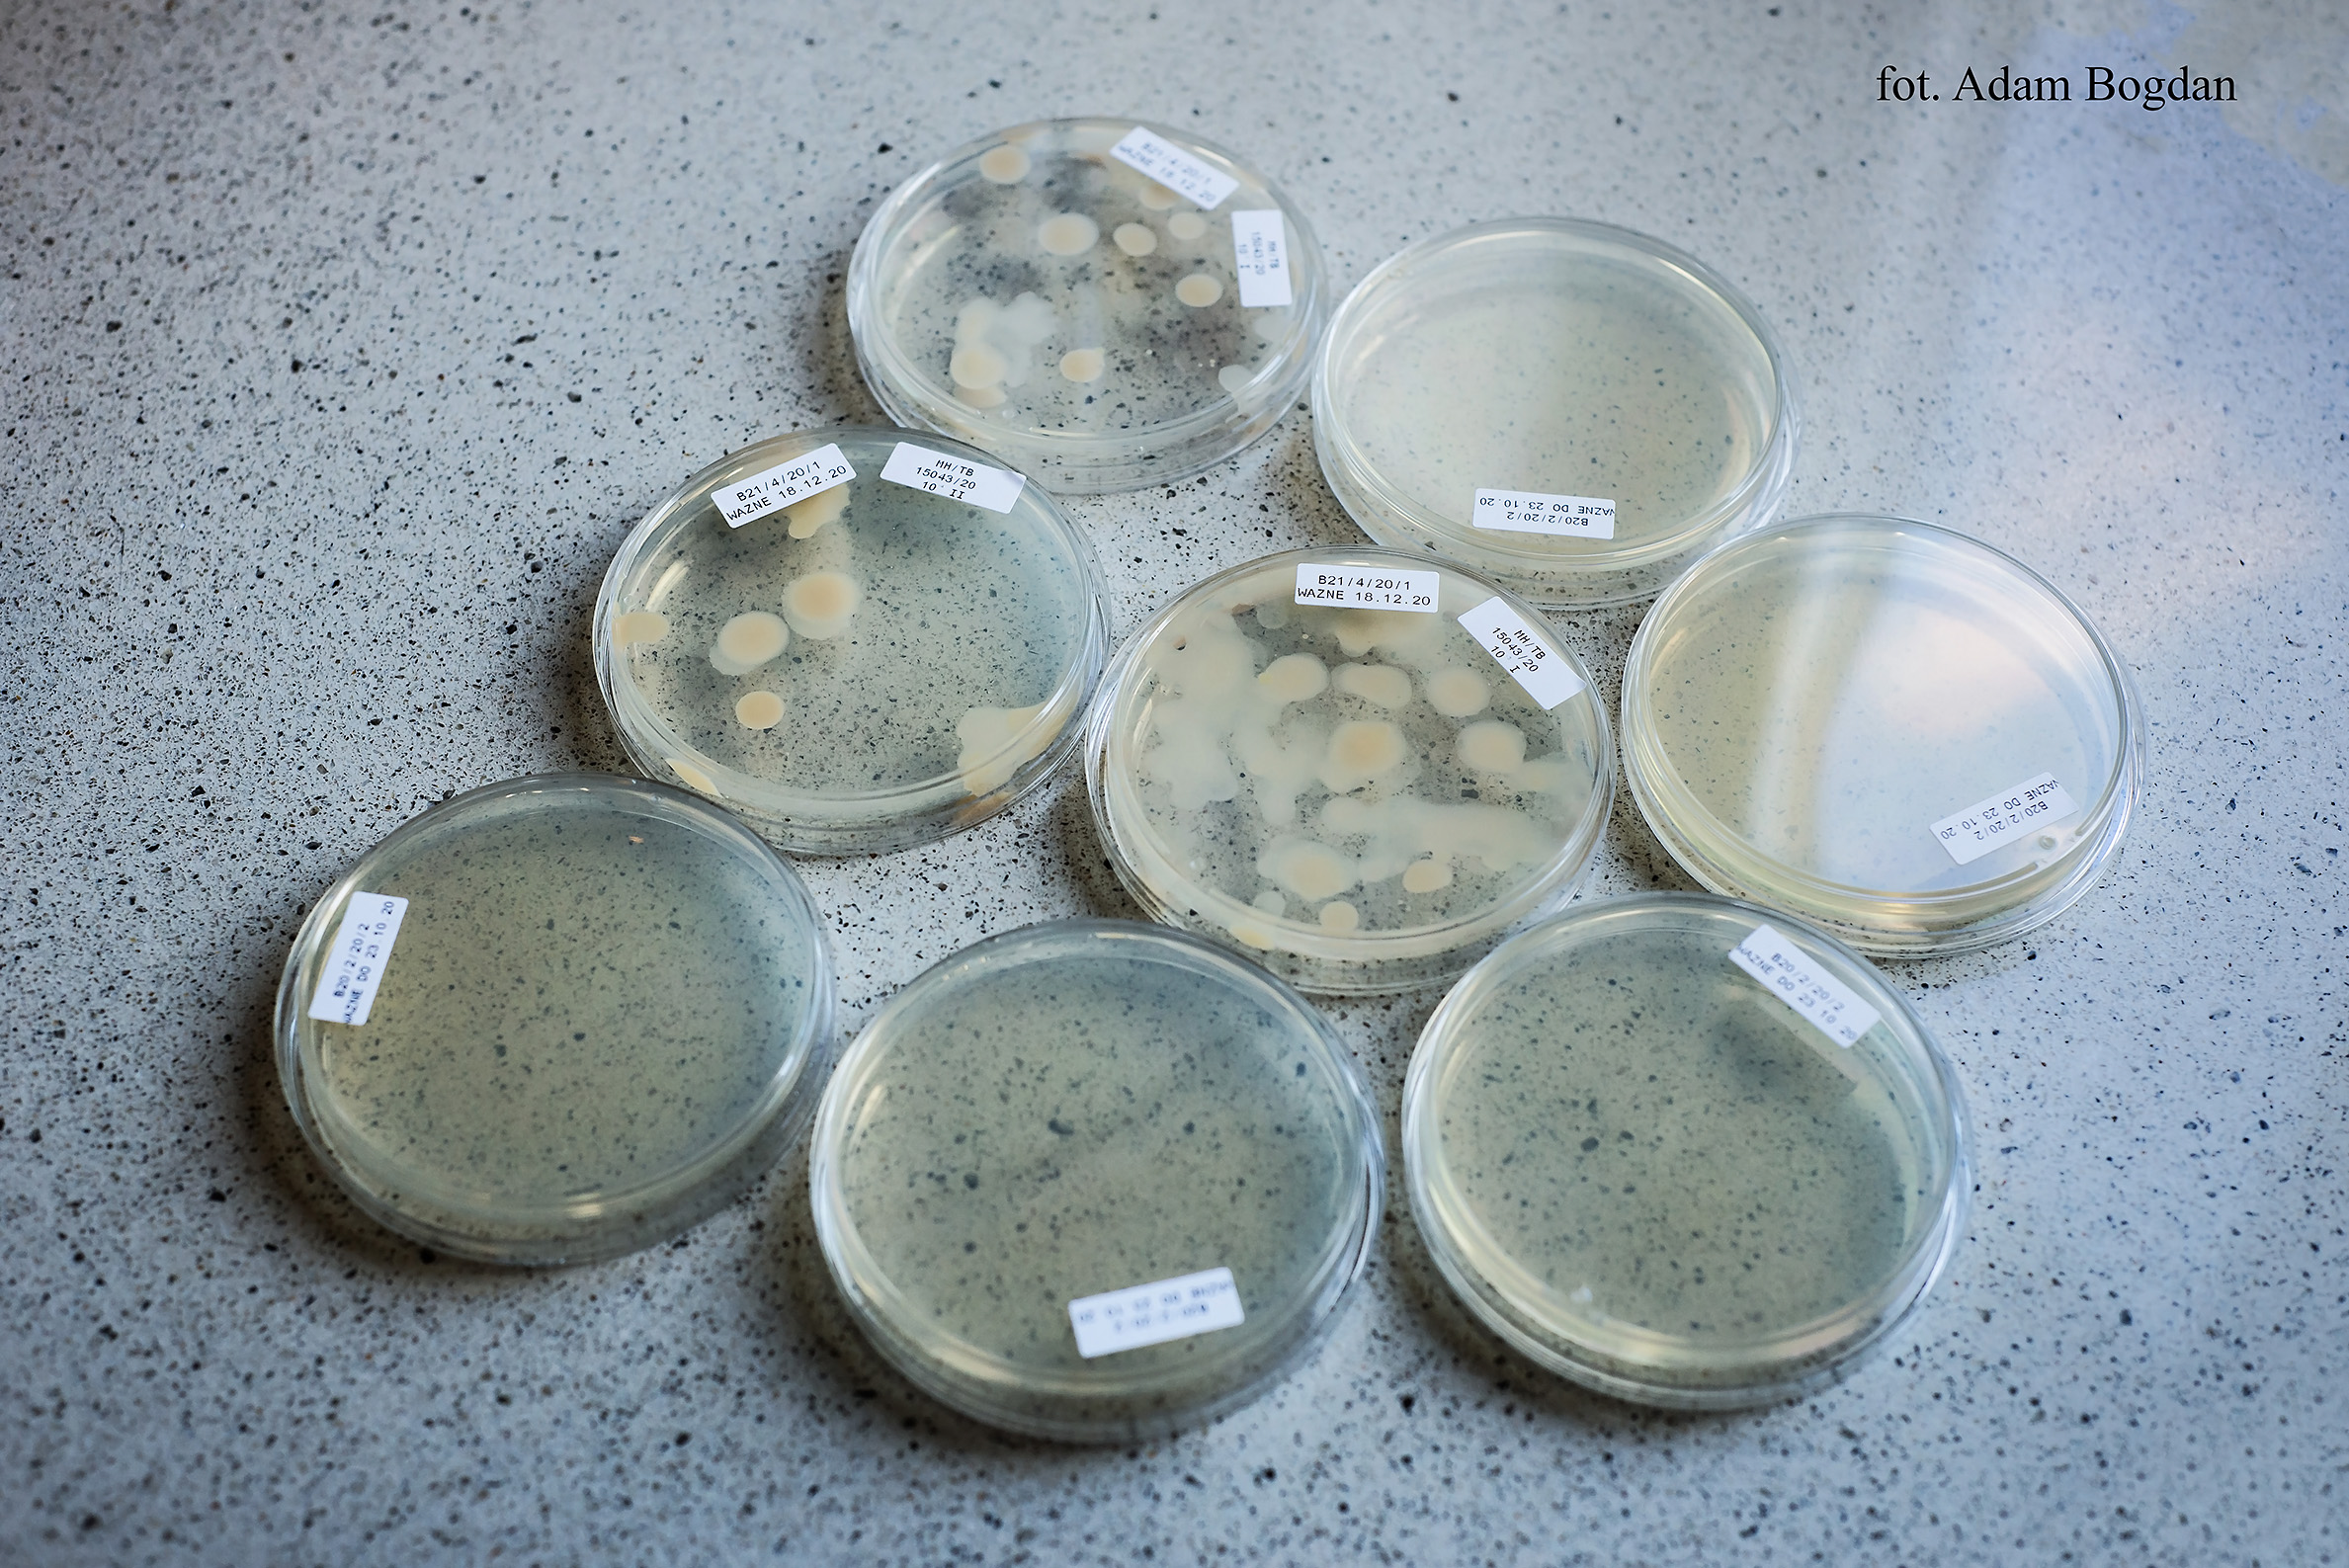

Pruszcz Gdański
Oddział Centralnego Laboratorium w Pruszczu Gdańskim

O laboratorium
Oddział Centralnego Laboratorium w Pruszczu Gdańskim wykonuje badania fitosanitarne.
Dane kontaktowe
Kierownik laboratorium - Agata Jędrzejewicz
tel. 734 116 122
e-mail: ocl-pruszcz-gdanski@piorin.gov.pl
tel. 734 116 166
tel. 734 116 169
Adres:
ul. Zygmunta Wróblewskiego 5
83-000 Pruszcz Gdański
Godziny urzędowania: 7:30 - 15:30
Materiały
Zakres badań w OCL Pruszcz GdańskiZakres_badań_OCL_16042025.pdf 0.28MB Zakres akredytacji OCL w Pruszczu Gdańskim
AB_1713_16042025.pdf 0.24MB Certyfikat akredytacji ISO17025 OCL w Pruszczu Gdańskim
pruszcz_gdański_certyfikat_akredytacji.pdf 0.10MB
Zdjęcia (15)
Pokaż zdjęcie 1 z galerii.
 Pokaż zdjęcie 2 z galerii.
Pokaż zdjęcie 2 z galerii.
 Pokaż zdjęcie 3 z galerii.
Pokaż zdjęcie 3 z galerii.
 Pokaż zdjęcie 4 z galerii.
Pokaż zdjęcie 4 z galerii.
 Pokaż zdjęcie 5 z galerii.
Pokaż zdjęcie 5 z galerii.
 Pokaż zdjęcie 6 z galerii.
Pokaż zdjęcie 6 z galerii.
 Pokaż zdjęcie 7 z galerii.
Pokaż zdjęcie 7 z galerii.
 Pokaż zdjęcie 8 z galerii.
Pokaż zdjęcie 8 z galerii.
 Pokaż zdjęcie 9 z galerii.
Pokaż zdjęcie 9 z galerii.
 Pokaż zdjęcie 10 z galerii.
Pokaż zdjęcie 10 z galerii.
 Pokaż zdjęcie 11 z galerii.
Pokaż zdjęcie 11 z galerii.
 Pokaż zdjęcie 12 z galerii.
Pokaż zdjęcie 12 z galerii.
 Pokaż zdjęcie 13 z galerii.
Pokaż zdjęcie 13 z galerii.
 Pokaż zdjęcie 14 z galerii.
Pokaż zdjęcie 14 z galerii.
 Pokaż zdjęcie 15 z galerii.
Pokaż zdjęcie 15 z galerii.

 Pokaż zdjęcie 2 z galerii.
Pokaż zdjęcie 2 z galerii.
 Pokaż zdjęcie 3 z galerii.
Pokaż zdjęcie 3 z galerii.
 Pokaż zdjęcie 4 z galerii.
Pokaż zdjęcie 4 z galerii.
 Pokaż zdjęcie 5 z galerii.
Pokaż zdjęcie 5 z galerii.
Pokaż zdjęcie 6 z galerii.
Pokaż zdjęcie 6 z galerii.
 Pokaż zdjęcie 7 z galerii.
Pokaż zdjęcie 7 z galerii.
 Pokaż zdjęcie 8 z galerii.
Pokaż zdjęcie 8 z galerii.
Pokaż zdjęcie 9 z galerii.
Pokaż zdjęcie 9 z galerii.
 Pokaż zdjęcie 10 z galerii.
Pokaż zdjęcie 10 z galerii.
 Pokaż zdjęcie 11 z galerii.
Pokaż zdjęcie 11 z galerii.
 Pokaż zdjęcie 12 z galerii.
Pokaż zdjęcie 12 z galerii.
 Pokaż zdjęcie 13 z galerii.
Pokaż zdjęcie 13 z galerii.
 Pokaż zdjęcie 14 z galerii.
Pokaż zdjęcie 14 z galerii.
 Pokaż zdjęcie 15 z galerii.
Pokaż zdjęcie 15 z galerii.
